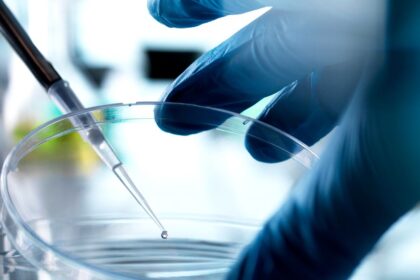

“Quando combinado com outros caminhos do Pacífico para a Austrália e a Nova Zelândia, quase 4 % da população poderia migrar a cada ano”, diz Jane McAdam, bolsista do Centro de Kaldor para a l...
Liu tem feito a solução em seu apartamento alugado em Pequim, misturando ácido cítrico com clorito de sódio, de acordo com um relato que ele compartilhou no início deste mês em sua sub -milha q...
Flórida é o Último estado para evitar a autoridade da Food and Drug Administration, permitindo que os pacientes acessem certo tratamentos com células-tronco que não foram rigorosamente avaliados ...
China, Índia e O Japão não são os únicos países do continente asiático que desejam se estabelecer no incipiente espaço economia. Coréia do Sul Também quer estar na corrida espacial e até pl...
Uma equipe de Os astrônomos descobriram uma figura curiosa no universo. São duas galáxias distantes colidindo entre si para formar uma estrutura maior. Da perspectiva da Terra, a junção dos disco...
Quando Donald Trump Voltado para a Casa Branca, os Estados Unidos estavam anos após o câncer, um esforço democrático multibilionário para metade da morte do câncer até 2047. Havia um tipo de im...
As autoridades de saúde dos EUA, da RFK Jr. em Down, fizeram algumas reivindicações selvagens. Veja se você pode nomear a pessoa responsável por essas cotações e factóides. Ver artigo original...
Depois do meu nascimento, Minha mãe se tornou alérgica ao mundo. Essa é a única maneira que eu sabia como colocá -lo. Tantas coisas poderiam desencadeá-la: carpete novo, refogadores de ar, plás...
O mundo do novo teorema de Bousso ainda se afasta de nosso universo de maneiras notáveis. Para a conveniência matemática, ele assumiu que há uma variedade ilimitada de partículas – uma suposiç...